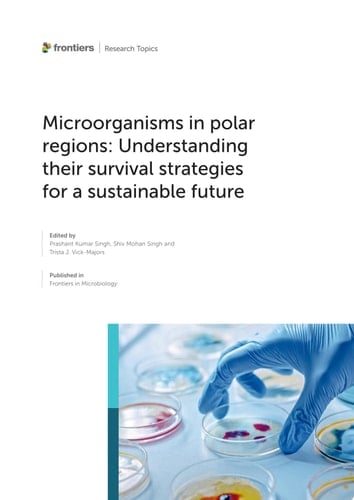
Microorganisms in Polar Regions: Understanding Their Survival Strategies for a Sustainable Future

Scientific research on cold-adapted microorganisms (specifically polar microbes) is of great interest, since Arctic and Antarctic regions harbor diverse and active populations of microorganisms. However, these microorganisms are subject to impacts of environmental perturbations. For example, climate change will modulate the distribution and activity of many cyanobacteria and algal species in polar environments that contribute significantly to global carbon fixation and oxygen production. Moreover, many microorganisms that have remained frozen for thousands of years can revive their metabolic activity and re-join the modern microbial community. For survival in freezing environments, polar microorganisms have established specific regulatory mechanisms which are now being challenged by new, rapidly changing environmental conditions. Remarkable progress has been made to uncover microbial adaptation to anthropogenic activities such as high irradiance, nutritional deprivation, UV-B radiation, heat, cold, desiccation, and heavy metals. Studies have enabled a basic understanding of gene regulatory pathways for morphological, physiological, metabolic, and genetic adaptations to various environmental stresses. To further elucidate physiological adaptation mechanisms and molecular diversity in polar regions, this Research Topic is focused on microbes in polar regions, looking at their biodiversity, ecological adaptations, the impact of climate change on their lifestyles, and biotechnological application of microbes for a sustainable future.
Page Count:
184
Publication Date:
2024-07-02
ISBN-10:
2832551114
ISBN-13:
9782832551110
No comments yet. Be the first to share your thoughts!